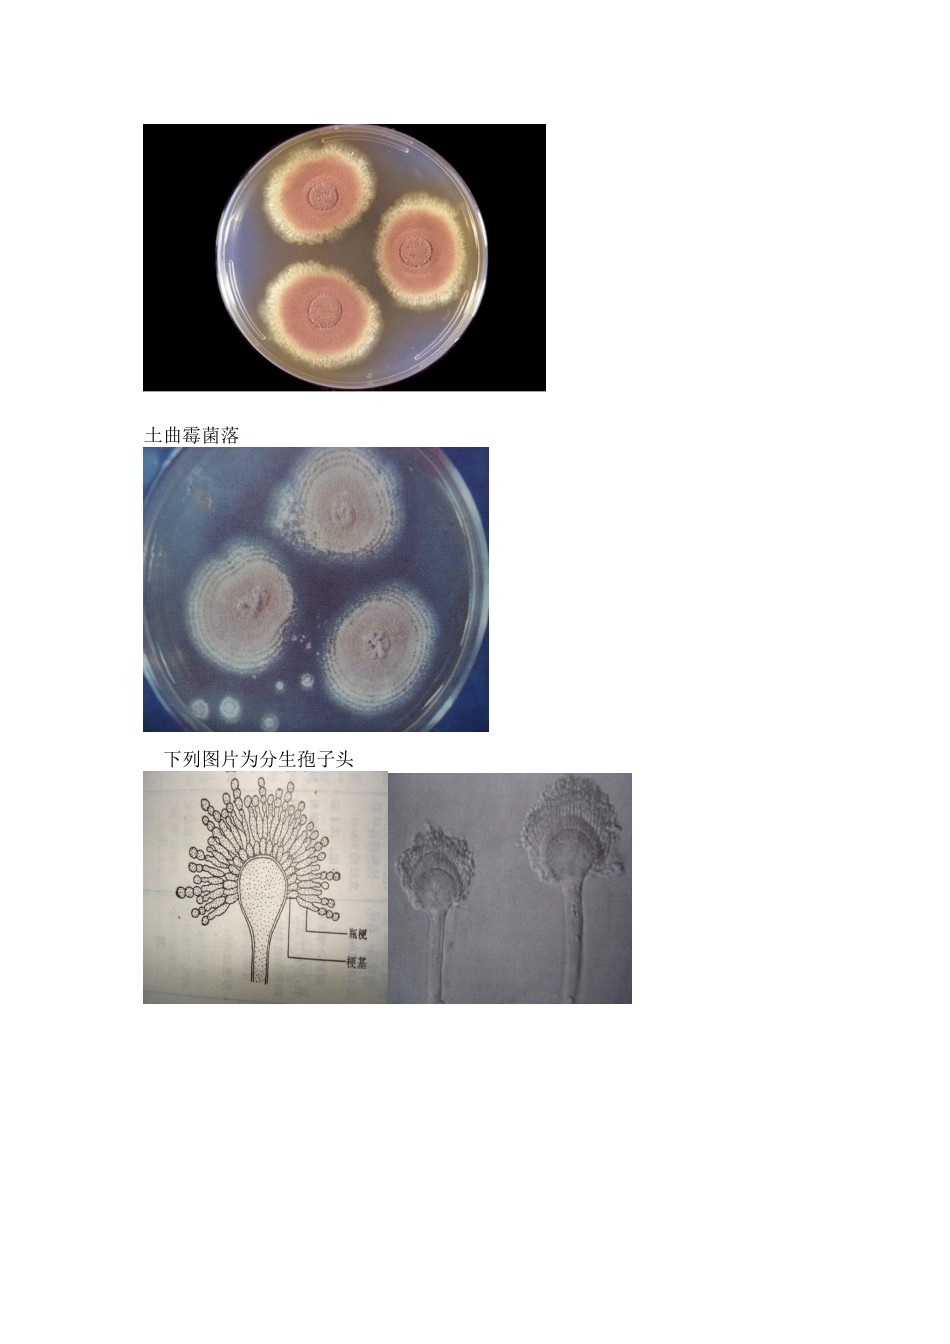
曲霉形态特征_第3页

几种曲霉得形态特征常见曲霉菌鉴定:菌落:菌落生长速度,表面质地、颜色、形态与气味等
其中颜色就是曲霉菌分类得依据之一② 分生孢子头:分生孢子头得形状、颜色与大小
分生孢子头由顶囊、瓶梗、梗基与分生孢子链组成,为曲霉得特征性结构 ③ 分生孢子梗或分生孢子柄:注意分生孢子梗得长短、颜色、表面粗糙或光滑、就是否有隔等 ④ 具有性生殖得曲霉能产生闭囊壳:为封闭式得薄壁子囊果,含子囊与子囊孢子; ⑤ 足细胞,也为曲霉得特征性结构
曲 霉 菌 得 结 构 1、烟曲霉菌 在 SD A培育基上菌落生长快,棉花 样,开始为白色,2~3 天后转为绿 色,数日后变为深绿色,呈粉末 状
分生孢子头得顶囊烧瓶状,小 梗单层,排列成木栅状,布满顶囊 表面 3/4,顶端有链形分生孢子,分生孢子球形,有小棘,绿色 烟曲霉菌菌落2、黄曲霉菌 在 S D A 培育基上菌落生长快,黄色,表面粉末状
分生孢子头顶囊球形或近球形,小梗双层,第一层长,布满顶囊表面,呈放射状排列,黄色,顶端有链形孢子 黄曲霉菌菌落黄曲霉菌分生孢子头3、土曲霉菌 在 SDA 培育基上菌落生长快,小,圆形,淡褐色或褐色
分生孢子头得顶囊半球形,小梗双层,第一层短,第二层长,呈放射状排列,分布顶囊表面2/3,顶端有链形孢子 土曲霉菌落 下列图片为分生孢子头4、黑曲霉菌 在 SDA 培育基上菌落生长快,表面黑色,粉末状
分生孢子头得顶囊球形或近球形,小梗双层,第一层粗大,第二层短小,呈放射状排列,布满整个顶囊,黑色,顶端有链形孢子 黑曲霉菌落黑曲霉分生孢子头 5、杂色曲霉菌 在 SDA 培育基上菌落生长慢,菌落圆形紧密,绒毛状,羊毛状,颜色有数环,从青绿到红绿
分生孢子头得顶囊近球形,小梗双层,第一层长,第二层短,呈放射状排列,布满顶囊4/5,顶端有链形孢子 杂色曲霉菌菌落杂色曲霉菌分生孢子头 下图为杂色曲霉菌分生孢子头电镜